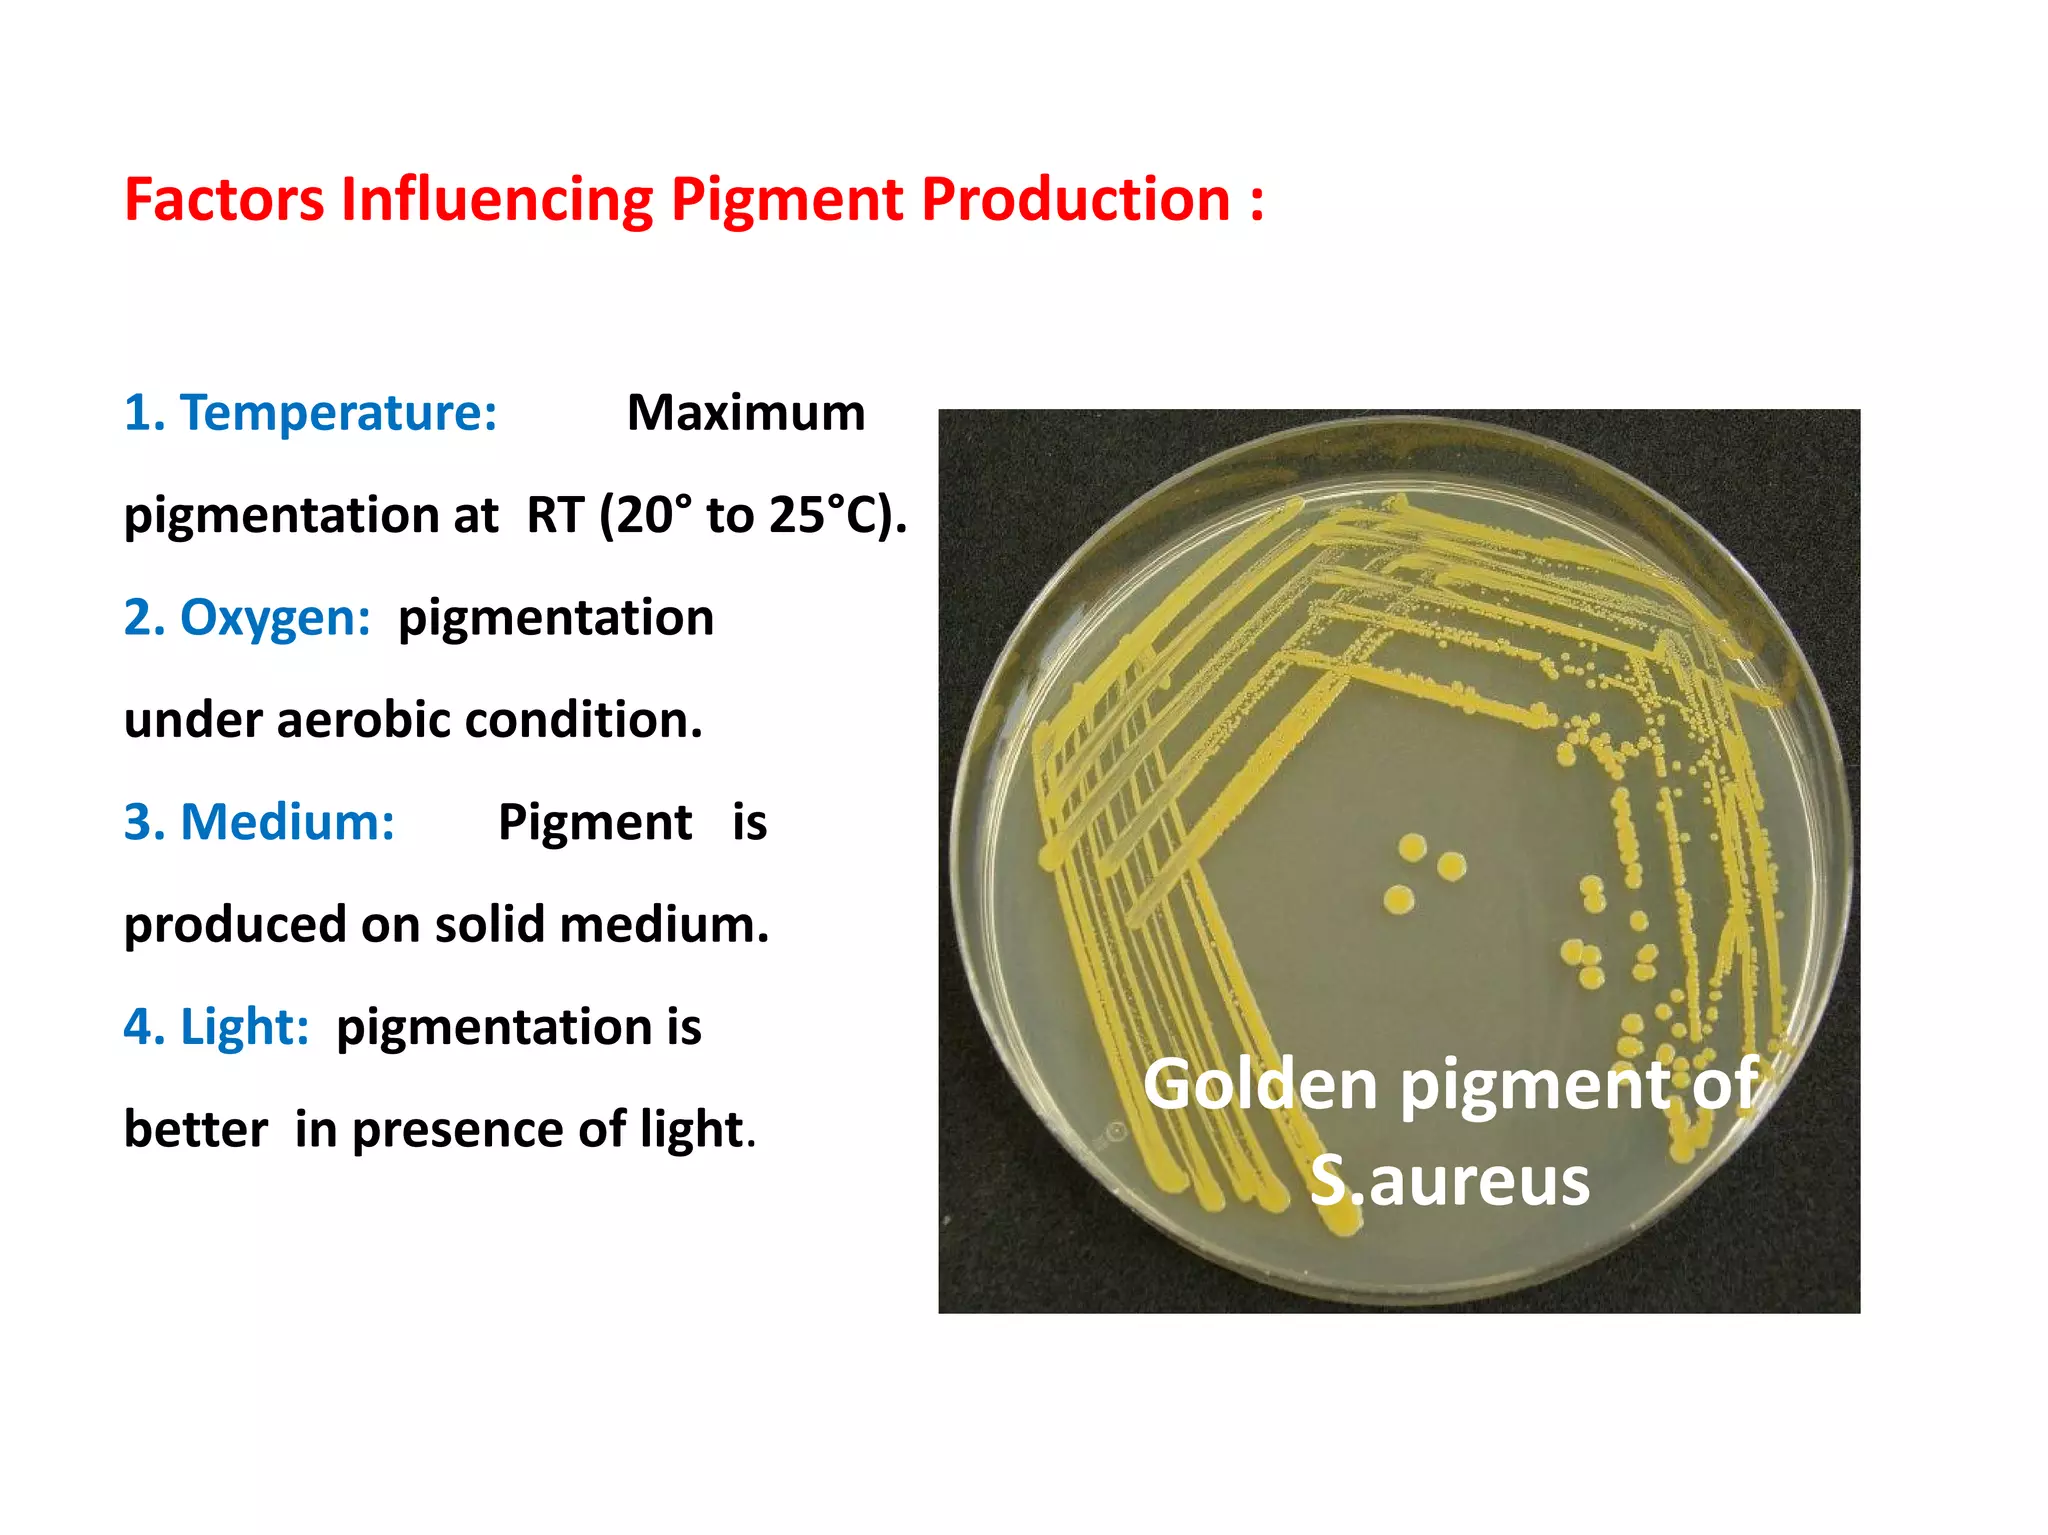
Factors Influencing Pigment Production :
1. Temperature: Maximum
pigmentation at RT (20° to 25°C).
2. Oxygen: pigmentation
under aerobic condition.
3. Medium: Pigment is
produced on solid medium.
4. Light: pigmentation is
better in presence of light.
Golden pigment of
S.aureus
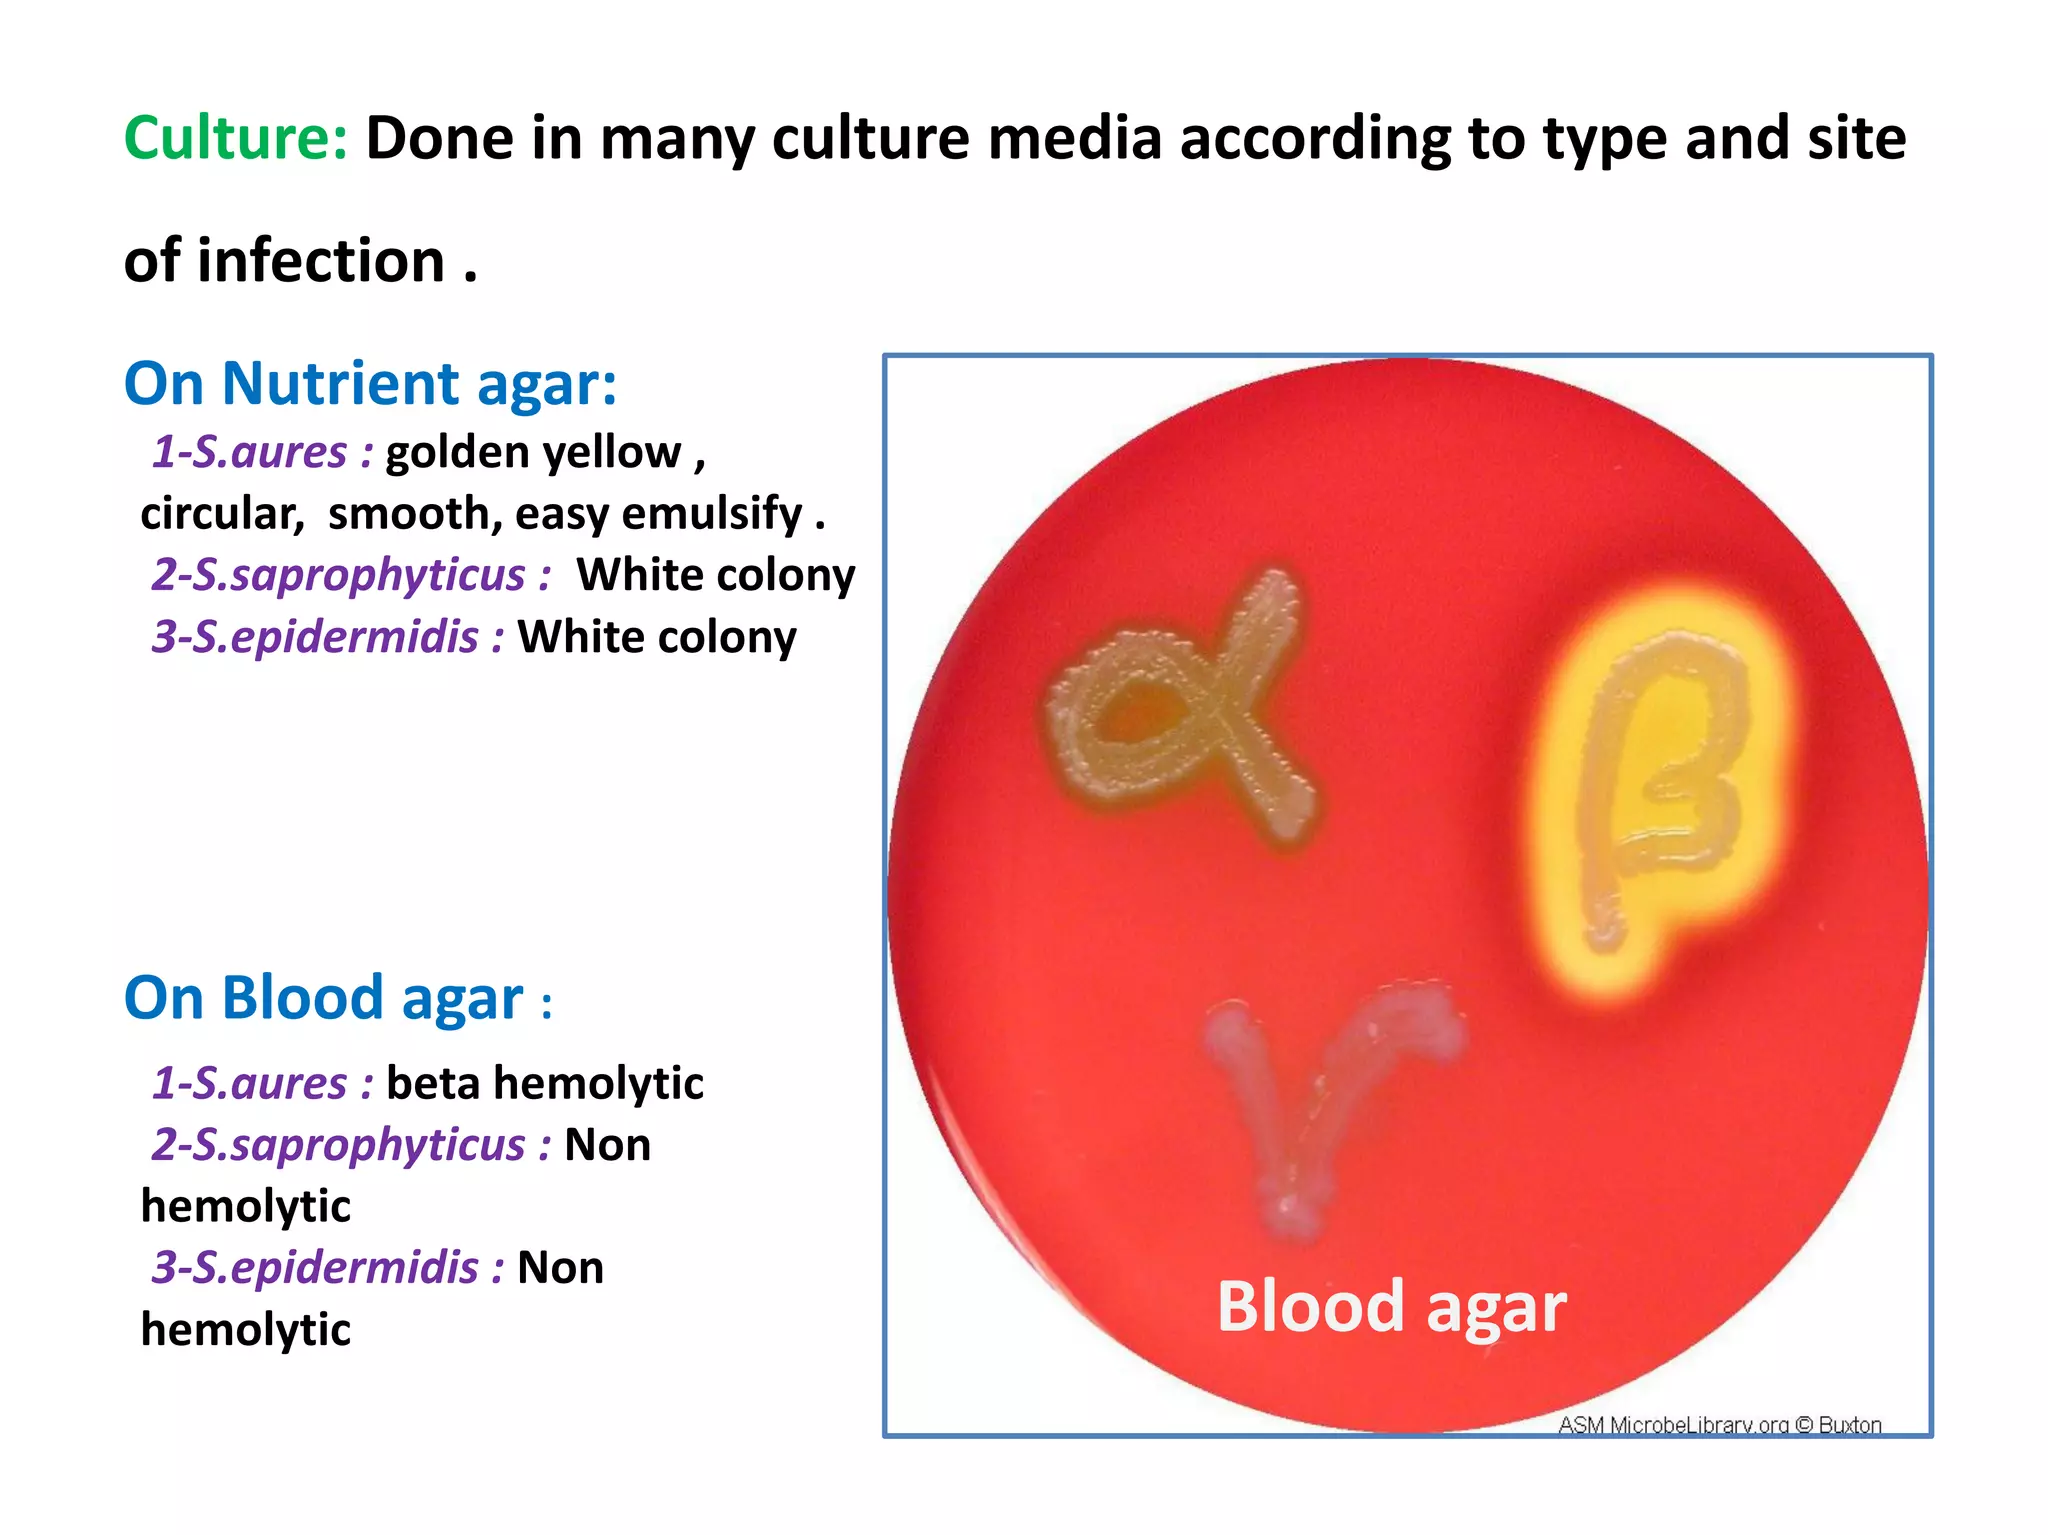
Culture: Done in many culture media according to type and site
of infection .
On Nutrient agar:
1-S.aures : golden yellow ,
circular, smooth, easy emulsify .
2-S.saprophyticus : White colony
3-S.epidermidis : White colony
On Blood agar :
1-S.aures : beta hemolytic
2-S.saprophyticus : Non
hemolytic
3-S.epidermidis : Non
hemolytic Blood agar
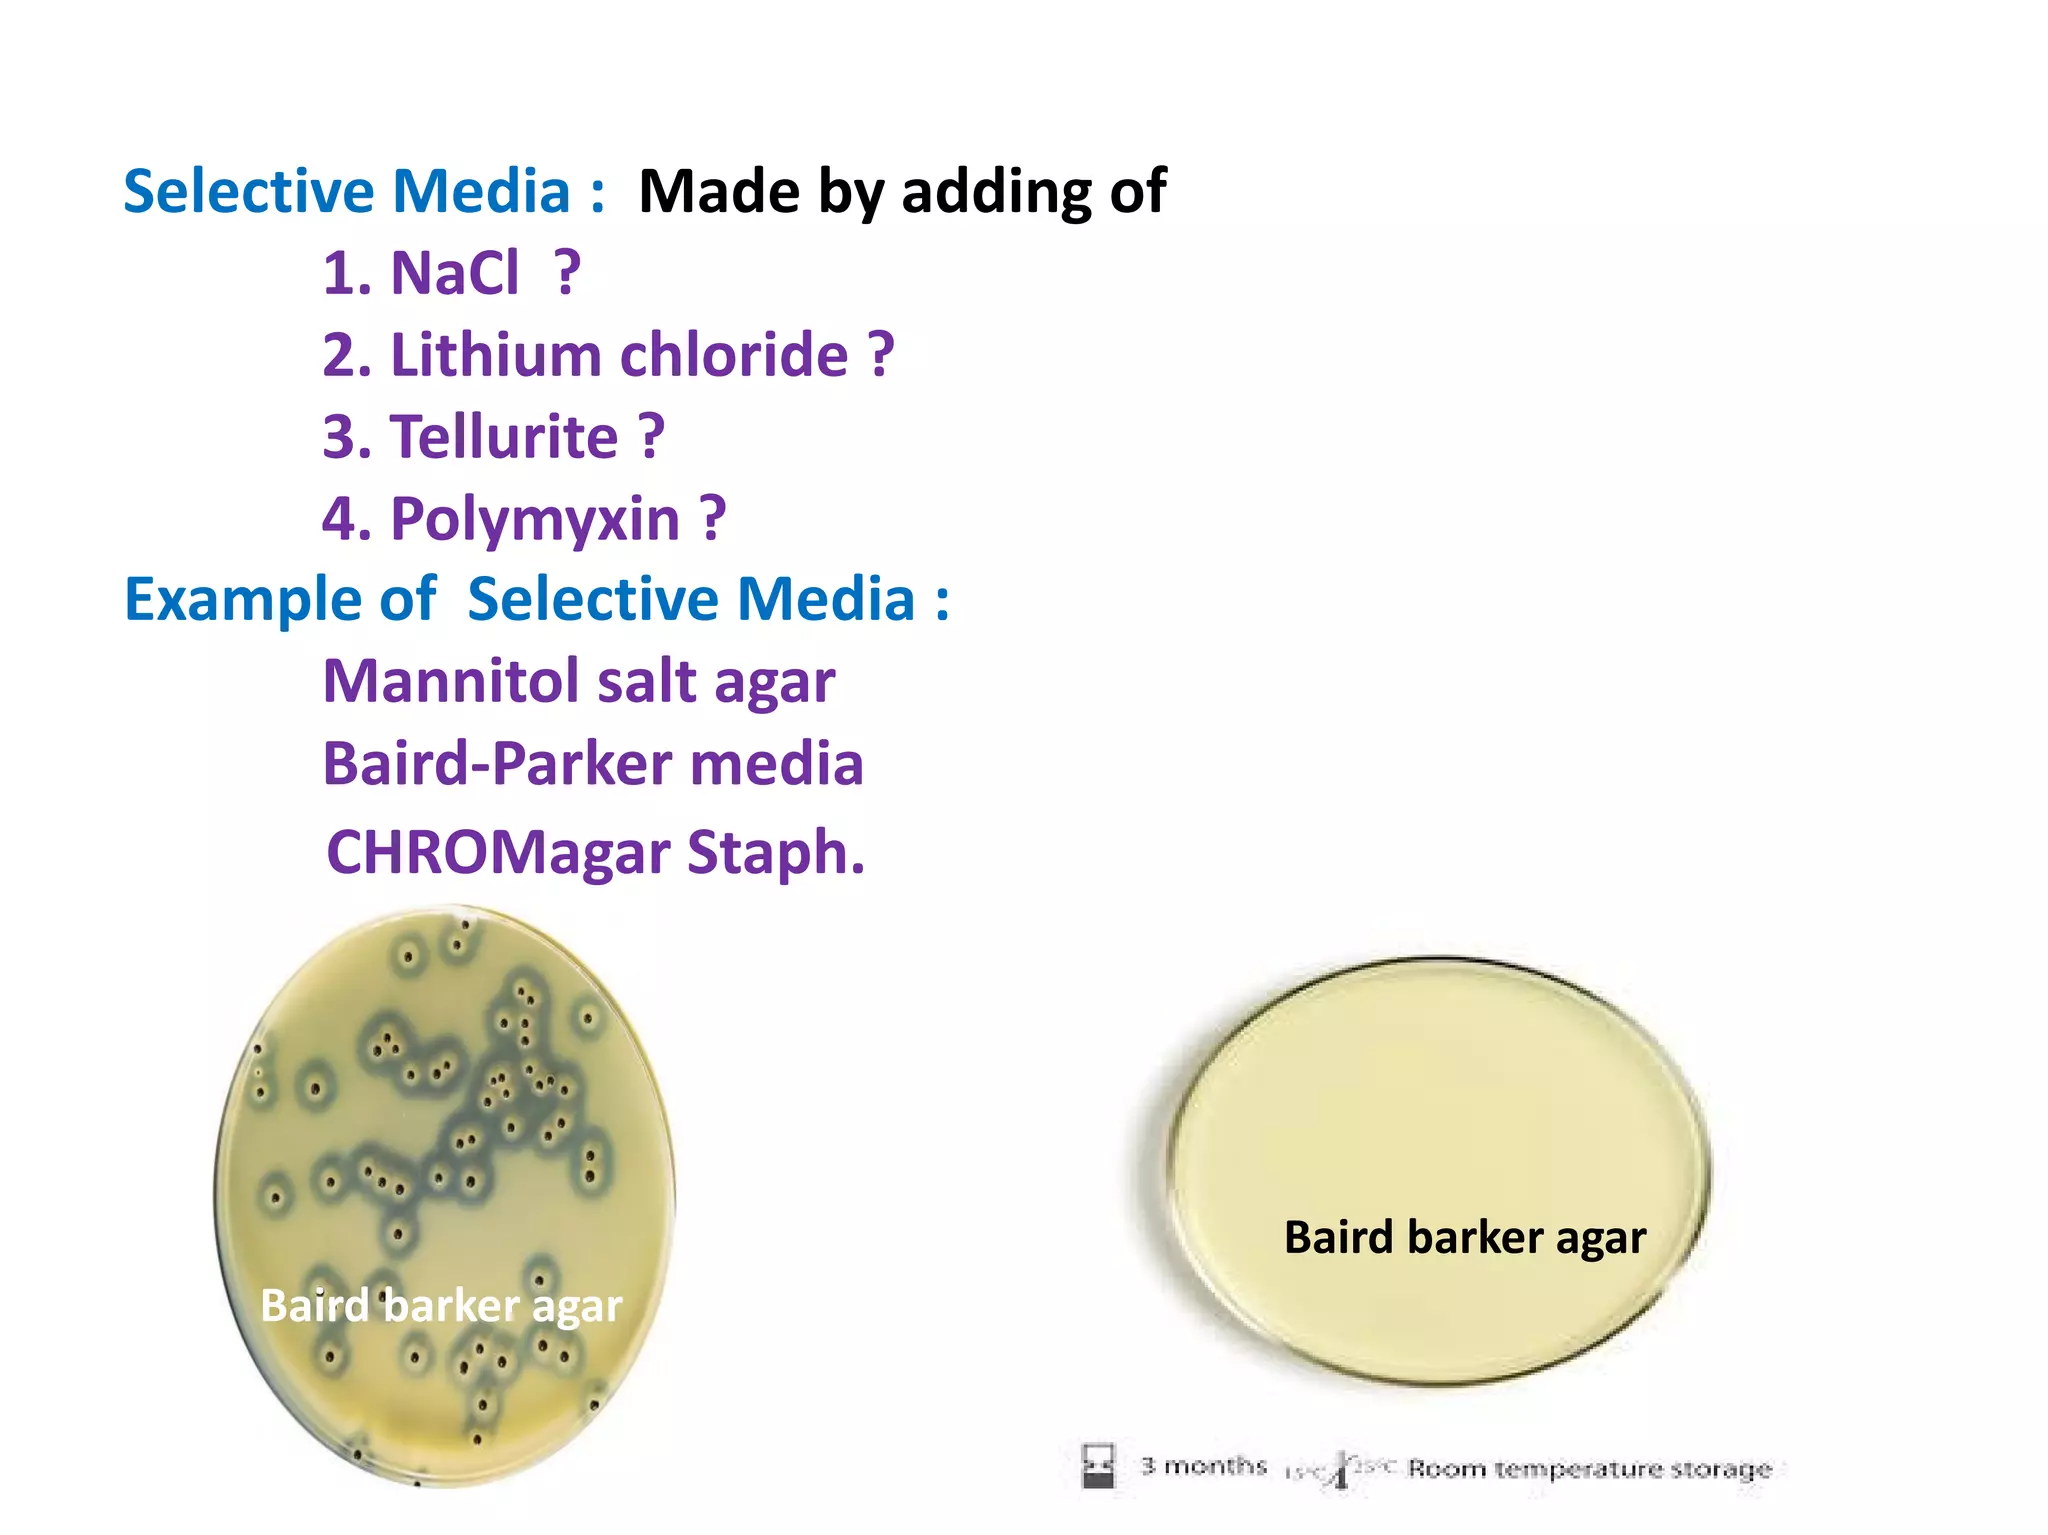
Selective Media : Made by adding of
1. NaCl ?
2. Lithium chloride ?
3. Tellurite ?
4. Polymyxin ?
Example of Selective Media :
Mannitol salt agar
Baird-Parker media
CHROMagar Staph.
Baird-Parker media
Baird barker agar
Baird barker agar
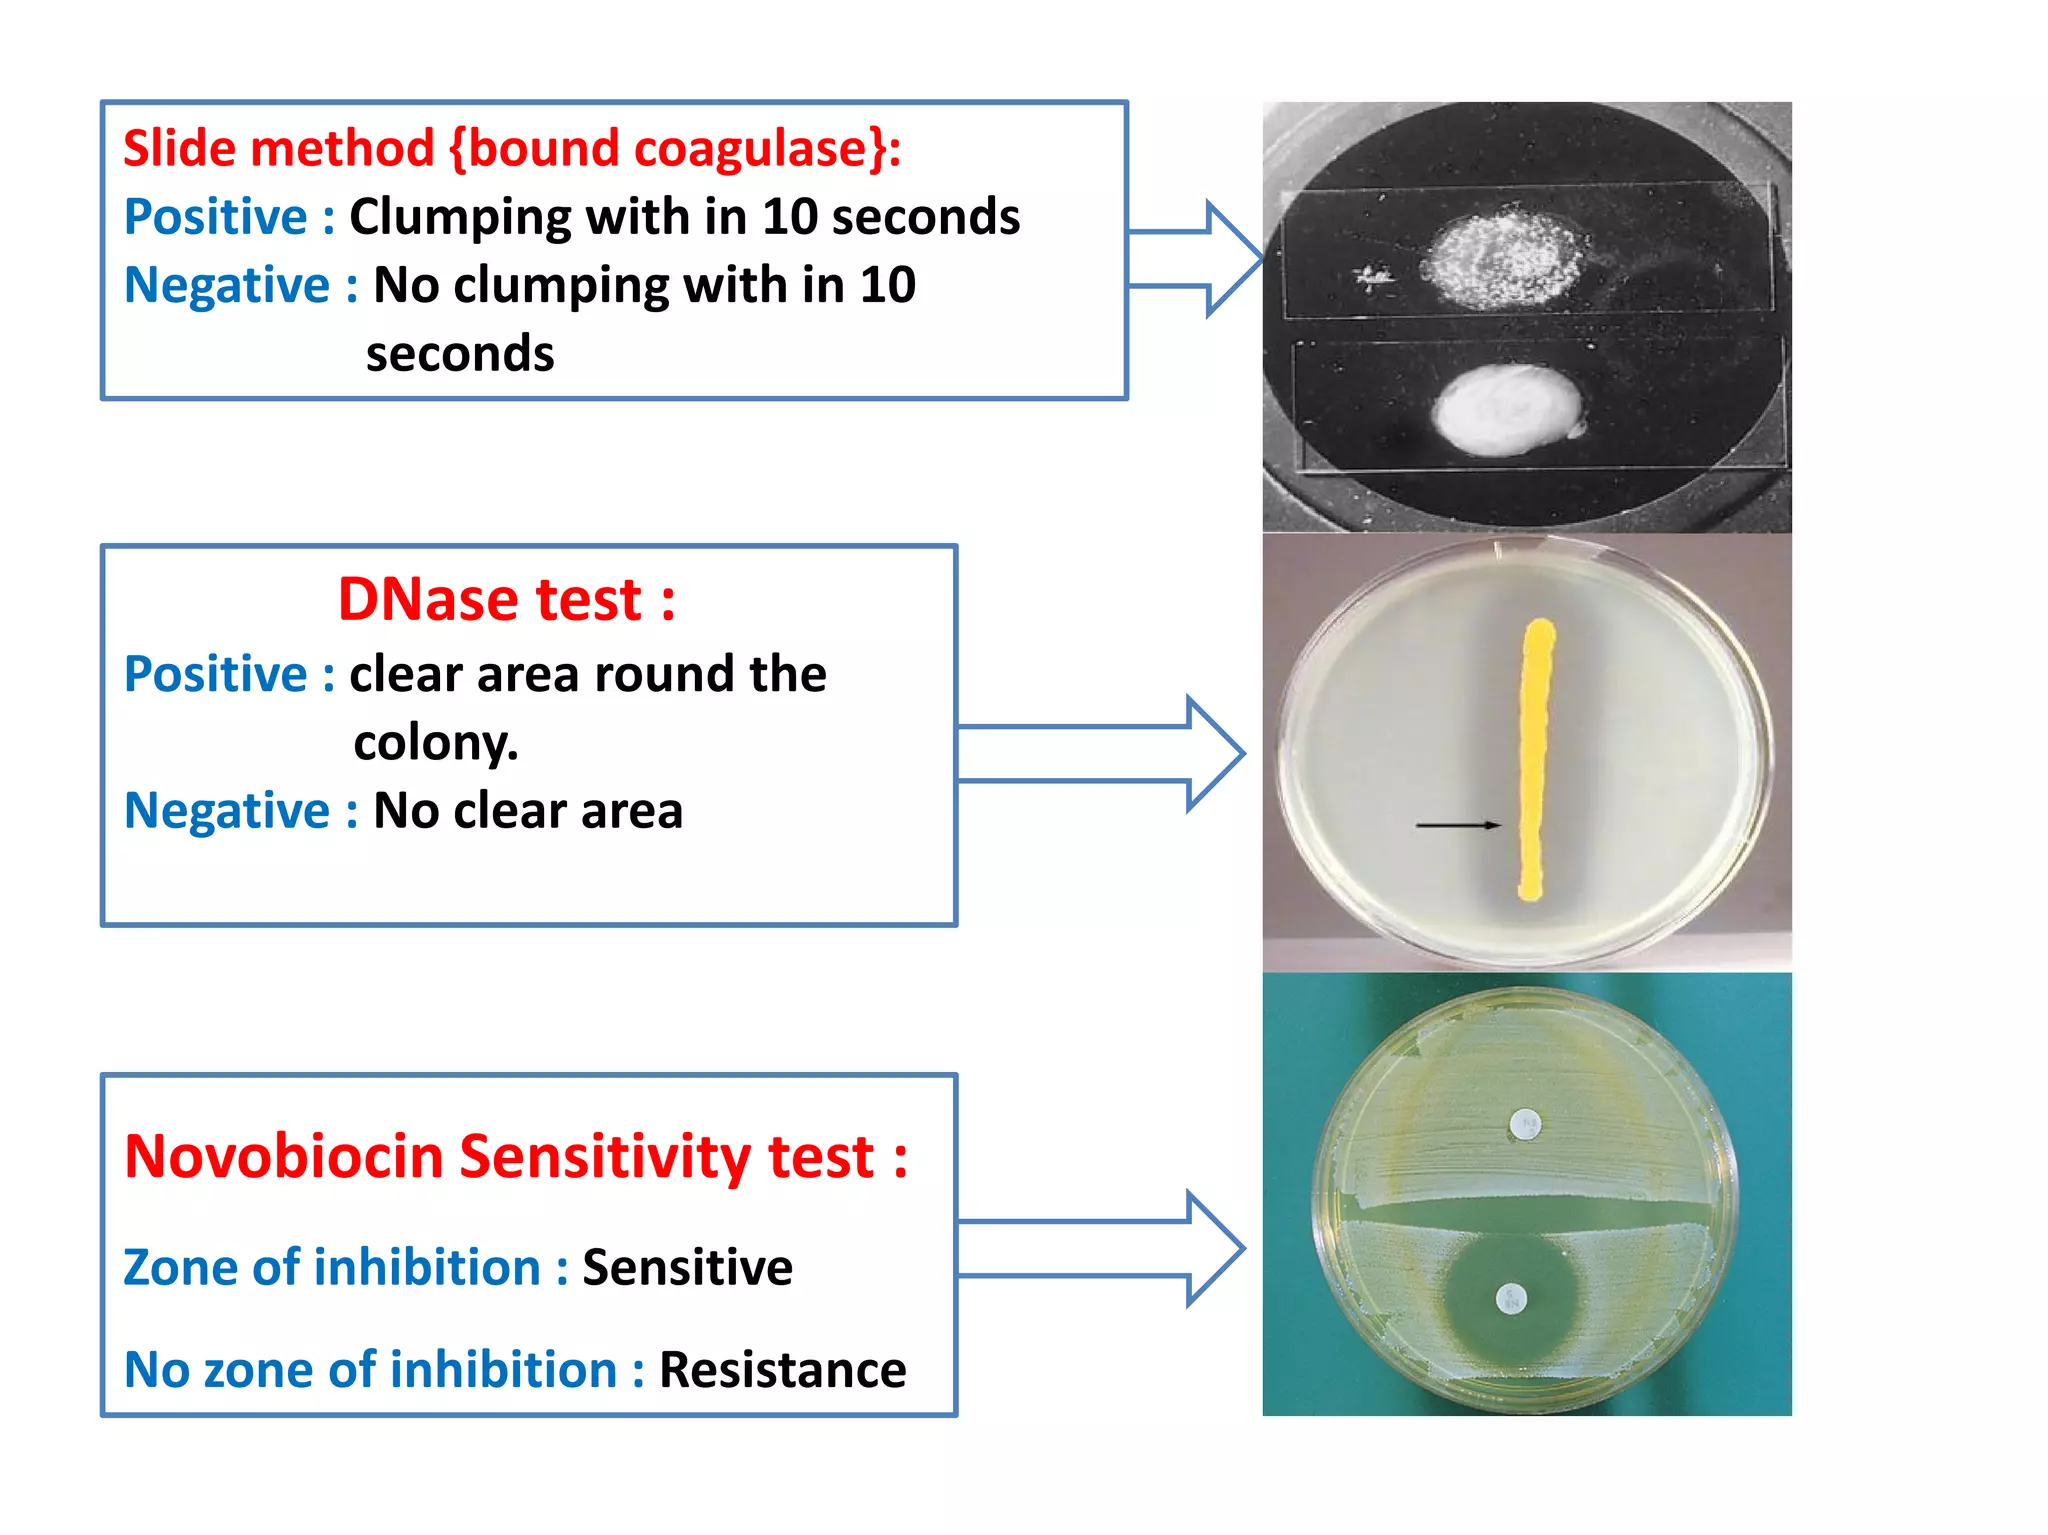
DNase test :
Positive : clear area round the
colony.
Slide method {bound coagulase}:
Positive : Clumping with in 10 seconds
Negative : No clumping with in 10
seconds
colony.
Negative : No clear area
Novobiocin Sensitivity test :
Zone of inhibition : Sensitive
No zone of inhibition : Resistance

The document provides a comprehensive overview of the Staphylococcus genus, detailing key properties, significant species like S. aureus, S. saprophyticus, and S. epidermidis, and their pathogenicity. It discusses laboratory diagnosis methods, including microscopy and culture techniques, alongside treatment options for staphylococcal infections. Key aspects like virulence factors and identification methods, including biochemical tests and automated systems, are also highlighted.